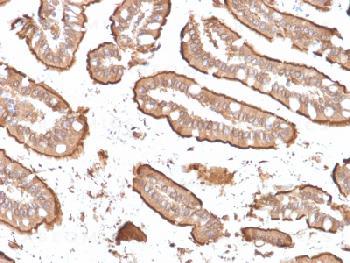

Anti-Villin (GI-Mucosal & Urogenital Brush Border Marker) Recombinant Mouse Monoclonal Antibody (Clone:rVIL1/1325)
Figure 1: Formalin-fixed, paraffin-embedded human Small Intestinal Carcinoma stained with Villin Mouse Recombinant Monoclonal Antibody (rVIL1/1325).
Roll over image to zoom in
Shipping Info:
For estimated delivery dates, please contact us at [email protected]
Format : | Purified |
Amount : | 100 µg |
Isotype : | Mouse IgG1, kappa |
Purification : | Protein A/G |
Content : | 200µg/ml of recombinant MAb purified by Protein A/G. Prepared in 10mM PBS with 0.05% BSA & 0.05% azide. Also available WITHOUT BSA & azide at 1.0mg/ml. |
Storage condition : | Antibody with azide - store at 2 to 8°C. Antibody without azide - store at -20 to -80°C. Antibody is stable for 24 months. Non-hazardous. |
Recognizes a protein of 95kDa, which is identified as villin. It is a major constituent in the microvilli, which compose the brush border of epithelial cells forming absorptive surfaces of the intestinal and renal proximal tubular epithelia. Anti-Villin labels the brush border area in the gastrointestinal mucosal epithelium and urogenital tract. Among neoplasms, villin is predominantly expressed in tumors of colorectal origin. Antibody to villin is useful in identifying malignant cells from primary and metastatic colorectal carcinomas. This antibody also labels Merkel cells of the skin.
Immunohistochemistry (Formalin-fixed) (1-2µg/ml for 30 minutes at RT)(Staining of formalin-fixed tissues requires heating tissue sections in 10mM Tris with 1mM EDTA, pH 9.0, for 45 min at 95°C followed by cooling at RT for 20 minutes);
For Research Use Only. Not for use in diagnostic/therapeutics procedures.
Subcellular location: | Cytoplasm, Cell projection, Cell projection, Cell projection, Cell projection, Cell projection |
Post transnational modification: | Tyrosine phosphorylation is induced by epidermal growth factor (EGF) and stimulates cell migration (By similarity). Phosphorylated on tyrosine residues by SRC. The unphosphorylated form increases the initial rate of actin-nucleating activity, whereas the tyrosine-phosphorylated form inhibits actin-nucleating activity, enhances actin-bundling activity and enhances actin-severing activity by reducing high Ca(2+) requirements. The tyrosine-phosphorylated form does not regulate actin-capping activity. Tyrosine phosphorylation is essential for cell migration: tyrosine phosphorylation sites in the N-terminus half regulate actin reorganization and cell morphology, whereas tyrosine phosphorylation sites in the C-terminus half regulate cell migration via interaction with PLCG1. |
Tissue Specificity: | Specifically expressed in epithelial cells. Major component of microvilli of intestinal epithelial cells and kidney proximal tubule cells. Expressed in canalicular microvilli of hepatocytes (at protein level). |
BioGrid: | 113270. 6 interactions. |
There are currently no product reviews
|